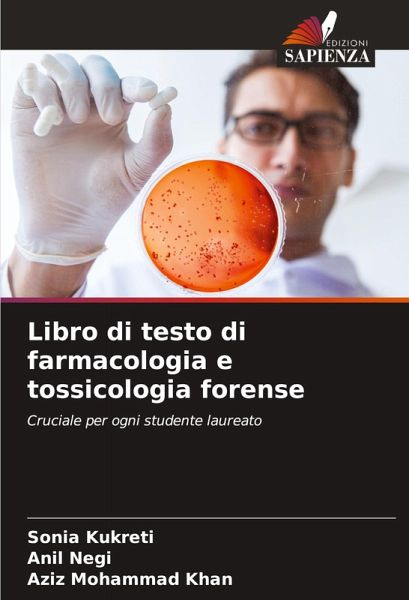
Libro di testo di farmacologia e tossicologia forense Libro di testo di farmacologia e tossicologia forense

Libro di testo di farmacologia e tossicologia forense
Cruciale per ogni studente laureato
Versandkostenfrei!
Versandfertig in 6-10 Tagen
29,99 €
inkl. MwSt.
PAYBACK Punkte
15 °P sammeln!
Questo libro di testo si propone di insegnare i fondamenti della tossicologia e della farmaceutica forense agli studenti indiani di medicina. Si tratta di un'ampia opera d'amore che cerca di presentare la materia nel modo più metodico e strutturato che si possa immaginare. Il progetto è quello di analizzare ogni minimo dettaglio alla ricerca di segni di abuso di droghe e sostanze inquinanti. Tutti i titoli del capitolo di base sulla medicina legale e la tossicologia sono chiaramente suddivisi in sottoargomenti e sottovoci.